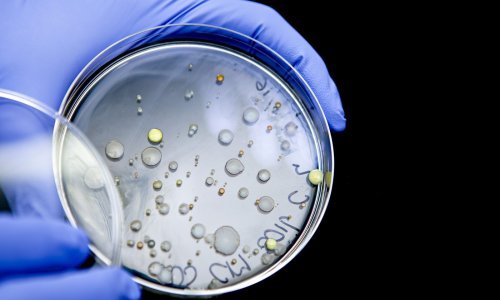

Američki su znanstvenici razvili revolucionarnu metodu borbe protiv bakterija koja bi mogla biti rješenje za brojne probleme liječenja infekcija koje iz godine u godinu postaju sve otpornije i predstavljaju sve veću opasnost za opstanak čovječanstva
Rat protiv bakterija u ovom je desetljeću postao toliko ozbiljan da je savjetnica britanske vlade za zdravlje prof. Dame Sally Davies 2013. upozorila da rezistencija bakterija na antibiotike predstavlja prijetnju čovječanstvu sličnu kao globalno zatopljenje ili terorizam.
Svijet bez antibiotika u kojem bi svaki porod ponovno bio opasan po život baš kao i svaka rana, upala ili operacija, teško i zamisliti, no mnogi stručnjaci upozoravaju da takve crne vizije budućnosti ne predstavljaju pretjerivanje.
Pedesete i šezdesete godine prošlog stoljeća bile su zlatno doba otkrića antibiotika no od 1987. nije otkriven niti jedan, a bakterije su u međuvremenu razvile zastrašujuću otpornost. Danas se u više od 80 zemalja širom svijeta bilježi ekstenzivno otporna tuberkuloza koja se ne može liječiti nijednim od postojećih lijekova, a superbakterija MRSA postala je baukom brojnih bolnica, čak i onih u razvijenim zemljama.
Prof. dr. sc. Arjana Tambić Andrašević iz Klinike za infektivne bolesti Fran Mihaljević istaknula je 2013. da Hrvatska po potrošnji antibiotika, a time i po rezistenciji spada u sam europski vrh. U našoj zemlji posljednjih se godina otkrivaju razni sojevi bakterija poput E. coli, MRSA, Klebsielle pneumoniae i Pseudomonasa koje su otporne na najsnažnije antibiotike karbapeneme.
Kako funkcionira nova metoda?
U novoj tehnici nazvanoj antibody-antibiotic conjugate (AAC), predstavljenoj u uglednom časopisu Nature, antibiotici se povezuju s antitijelima koja reagiraju na ciljane uzročnike bolesti. Antitijela odvlače antibiotike do bakterija i ondje ih otpuštaju. Na taj način postiže se više ključnih efekata: antibiotik djeluje samo na bakterije koje se želi napasti, a ne na korisne; učinak antibiotika je mnogo jači; konzumacija antibiotika ne potiče stvaranje otpornosti; lijek bolje pronalazi bakterije i temeljitije ih uništava, čak i sakrivene; u borbu protiv patogena mogu se uključiti brojni djelotvorni antibiotici koji se ranije nisu smjeli koristiti jer su bili previše toksični itd.
Testovi na životinjama pokazali su da ova radikalna kombinacija neusporedivo efikasnije uništava superbakteriju poznatu kao zlatni stafilok ili MRSA od moćnog antibiotika vankomicina koji se inače koristi za liječenje teških infekcija opasnih po život, a primjenjuje se intravenski.
Infekcije zlatnim stafilokokom vrlo se teško liječe jer su neki sojevi otporni na antibiotike, a drugi se teško uklanjaju jer se bakterije uvlače i skrivaju u stanicama tijela. Mnogi lijekovi gube djelotvornost kada uđu u stanice.
Voditelj istraživanja Sanjeev Mariathasan iz Genentech u San Franciscu i njegov tim ovaj su problem riješili tako što su antitijela koja prepoznaju zlatne stafilokoke kemijskim mostom povezali s moćnim antibioticima sličnima rampamicinu. Most je tako konstruiran da puca kada dođe u kontakt s enzimima koji nastaju kada bakterije inficiraju stanice. Na taj način lijek postaje djelotvoran samo kada naiđe na bakterije koje napadaju stanice i pokušavaju se sakriti u njima.
Mariathasan kaže da je njihova tehnika spremna za klinička testiranja na ljudima. Ona bi, ističe, trebala omogućiti da se u borbi protiv bakterija upotrijebe brojni antibiotici koji nikada nisu došli u ljekarne jer su bili previše toksični ili u tijelu nisu bili dovoljno moćni.
'Imamo jako puno lijekova protiv stafilokoka koji nisu ugledali svjetlo dana jer nemaju sva svojstva koja lijekovi moraju imati', rekao je Mariathasan. 'Možda morate koristiti velike doze što uzrokuje toksičnost pa lijek odlično ubija mikrobe, ali također uzrokuje oštećenja na stanicama tijela. Na ovaj način možete uzeti jednu stotninu molekule i usmjeriti je točno prema mjestu infekcije. To je novi način da se ranije odbačeni antibiotici prenamijene', pojasnio je.